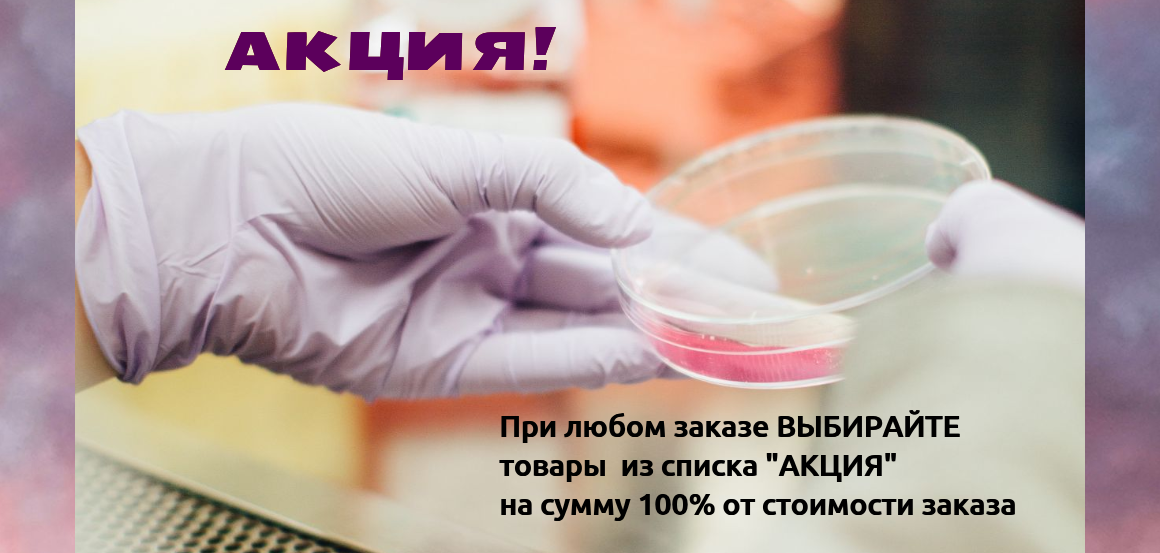
Лабораторный пластик ДАРОМ! Подарки за заказ!

Нойкем - наконечники, пробирки, планшеты, культуральный и ПЦР-пластик для Ваших лабораторий!
Новинки
Все новинки
Скидка!
Все товары со скидкой
Распродажа товаров со склада
Все товары...
Хиты продаж
Все товары...
Актуальное наличие всех товаров на складе ООО "Нойкем" можно скачать здесь: